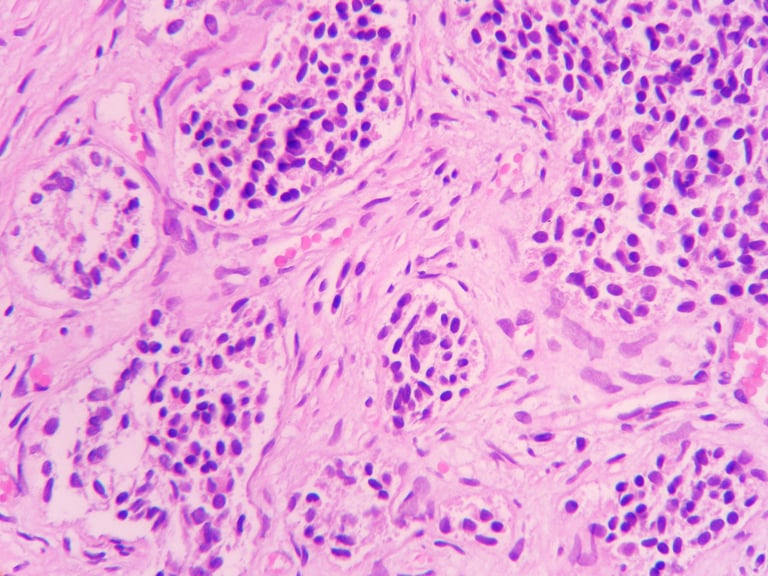
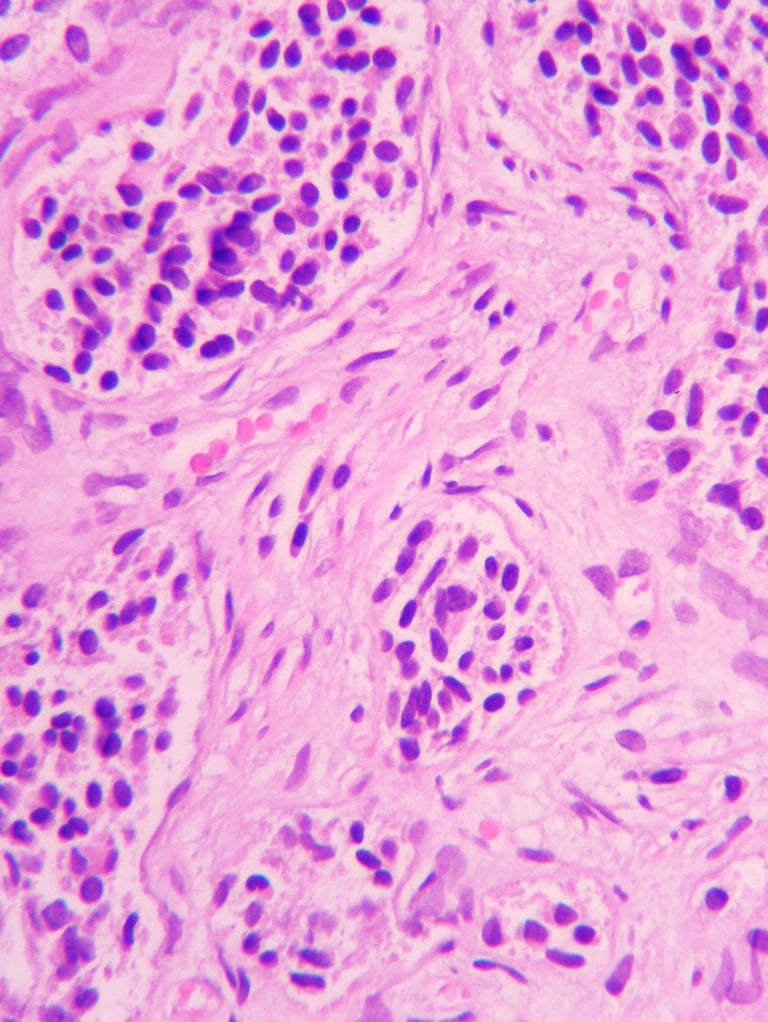

Фокальна терапія в лікуванні локалізованого раку передміхурової залози: біполярна радіочастотна абляція - новий, ефективний та малоінвазивний метод знищення неагресивних пухлин простати до 2 см
Не всі пухлини передміхурової залози потребують радикального лікування. Фокальна терапія — сучасний підхід для неагресивних форм раку.
Записуйтесь на консультацію до провідних онкоурологів України з приводу лікування раку простати в "Центр сучасної урології" Київ, вул. Васильківська 45.
Далі про біполярну абляцію простати розкаже автор методики, лікар-онкоуролог, професор Стаховський Едуард Олександрович.

Проблема гіперлікування раку простати - коли пацієнти отримують агресивне лікування без реальної потреби


Однією з серйозних проблем раку передміхурової залози є гіпердіагностика та гіперлікування - розповідає професор, лікар-онкоуролог, Стаховський Едуард Олександрович.
Гіперлікування раку передміхурової залози — це проведення лікування, яке не приносить клінічно значущої користі пацієнтові, але водночас може спричиняти побічні ефекти, які призводять до зниження якості життя та зайвих витрат.
Однак після встановлення діагнозу "рак / аденокарцинома передміхурової залози" деякі пацієнти отримують агресивне лікування без реальної потреби.
До гіперлікування належать:
Радикальна простатектомія при низькоризиковому раку;
Променева терапія без чітких показань;
Андроген-деприваційна терапія (гормонотерапія) при локалізованому низькоагресивному процесі;
Поєднання кількох методів лікування, коли достатнім було б спостереження.
Можливі наслідки гіперлікування:
нетримання сечі;
еректильна дисфункція;
порушення роботи кишківника;
гормональні розлади (остеопороз, метаболічні зміни);
психологічний стрес та зниження якості життя.
Гіперлікування особливо актуальне у випадках, коли пухлина не є агресивною: пацієнт може жити з таким діагнозом 10–20 років і померти не від раку простати, а від інших захворювань.
Саме тому при неагресивних формах пухлин надзвичайно важливо впроваджувати сучасні методи лікування, які не потребують значних витрат і мінімізують фізичне навантаження на пацієнта.
Фокальна терапія розглядається як потенційна альтернатива гіперлікуванню раку передміхурової залози.
При неагресивному раку передміхурової залози важливо уникати гіперлікування.
Фокальна терапія дозволяє ефективно лікувати пухлину, зберігаючи якість життя пацієнта.
}


Що таке фокальна терапія


Фокальна терапія — це локальне знищення лише клінічно значущого пухлинного вогнища, а не всієї передміхурової залози, з максимально можливим збереженням:
еректильної функції
континенції – утримання сечі
якості життя
Фокальна терапія ефективна на ранніх стадіях раку
Це новий напрям у лікуванні злоякісних новоутворень передміхурової залози, які діагностуються на ранніх стадіях.
Коли пухлина в передміхуровій залозі має невеликі розміри (до 1–2 см), можливо виконати фокальну терапію та знищити новоутворення без видалення простати.
Як правило, це малоінвазивні втручання, що передбачають використання різних видів обладнання та енергії. Незважаючи на відмінності методик, усі вони демонструють клінічну ефективність.
У багатьох країнах уже створюються спеціалізовані інститути фокальної терапії, які займаються лікуванням пухлин різної локалізації, мають значний потік пацієнтів і демонструють переконливі результати.
Одним із таких методів лікування є радіочастотна абляція пухлин передміхурової залози, розроблена нами в "Центрі сучасної урології" в Києві - наголошує професор Стаховський Е.О.


Фокальна терапія — сучасне лікування раку простати на ранніх стадіях без видалення самої передміхурової залози.
}


Біполярна радіочастотна абляція простати в Центрі сучасної урології в Києві


У нашому Центрі сучасної урології в Києві ми розробили метод біполярної радіочастотної абляції передміхурової залози.
Метод передбачає використання спеціальної біполярної голки, під час введення якої між двома електродами проходить струм, що викликає локальну деструкцію (руйнування) пухлини.
На відео видно, як зона біля голки світлішає.
На сьогодні ми маємо понад 100 виконаних втручань із добрими клінічними результатами. Ми отримуємо хороші результати.
Власний досвід дозволив нам чітко визначити показання та обмеження до застосування методики. За правильно підібраних пацієнтів ми досягаємо стабільно високих результатів лікування. І досягаємо успіхів.
Яким пацієнтам з раком простати може підійти такий метод?
Критерії відбору пацієнтів для фокальної терапії:
Показник Глісона (морфологічний): 6–7
Розмір пухлини: до 1 см (максимально допустимо — до 1,5–2 см)
Локалізація пухлини: в одній частці передміхурової залози або, у виняткових випадках, у двох частках за наявності окремих вогнищ
Бажання пацієнта пройти фокальне лікування


Як довго триває втручання на простаті?
Сама абляція триває недовго — 20–30 хвилин і проводиться під внутрішньовенною анестезією.
У «Центрі сучасної урології» працюють висококваліфіковані лікарі-анестезіологи, які забезпечують постійний нагляд за пацієнтом 24/7.


Як швидко додому?
Після цього малоінвазивного втручання пацієнт може виписатися зі стаціонару та повернутися додому в той самий день.
Коли пацієнт відновлює самостійне сечовипускання, ми його відпускаємо додому.


Після цієї операції організм сам відновлює нормальну простату
Під час фокальної терапії відбувається контрольоване руйнування пухлинних клітин.
У зоні впливу змінюється структура клітинних білків, пошкоджуються клітинні мембрани, і патологічна тканина поступово втрачає життєздатність.
Після процедури організм самостійно виводить зруйновані клітини, а навколишні здорові тканини простати зберігаються.
Лікувальний ефект досягається не лише завдяки температурному впливу, а й завдяки активації природних захисних механізмів організму, що сприяє контролю росту ракових клітин.
І все це разом дає хороший результат.


Клінічний випадок: лікування аденокарциноми передміхурової залози, 6 балів за Глісоном (3+3)
Пацієнт Б., 64 роки, звернувся до «Центру сучасної урології» зі скаргами на дизуричні розлади та ніктурію до 2–3 разів за ніч.
Ніктурія — це стан, коли людина прокидається вночі два або більше разів для сечовипускання, що порушує сон і призводить до втоми та зниження працездатності.
Рівень простатспецифічного антигену (ПСА) на момент звернення (baseline) становив 9 нг/мл, що перевищує рекомендовані вікові референтні значення (до 4,5–5,0 нг/мл) для чоловіків 60–69 років.
За даними мультипараметричної МРТ було виявлено новоутворення розмірами 12×13×8 мм у лівій частці передміхурової залози, в ділянці верхівки.
За результатами патогістологічного дослідження після 12-точкової біопсії встановлено діагноз: аденокарцинома передміхурової залози, 6 балів за Глісоном (3+3), G1, із ураженням приблизно 25% тканини у трьох біоптатах.
Пацієнту була виконана біполярна фокальна абляція пухлини простати.




Протягом двох років спостереження рівень ПСА знизився з 9 нг/мл до 1,1 нг/мл, що є нормальним показником для пацієнтів цього віку.
За даними контрольного МРТ, проведеного через рік після фокальної терапії, патологічних вогнищ не виявлено.
Повторна біопсія підтвердила наявність чітко окресленої ділянки склерозу в зоні проведеного лікування без ознак злоякісного процесу.


Можна одночасно лікувати ракову пухлину та аденому простати
Одночасне лікування раку та аденоми простати
Перевага цієї методики полягає у її подвійному лікувальному ефекті.
Як правило, рак передміхурової залози поєднується з аденомою простати.
Фокальна терапія дозволяє точково зруйнувати злоякісну пухлину, а також сприяє зменшенню об’єму аденоми передміхурової залози.
Таким чином, методика дає можливість одночасно лікувати як рак простати, так і аденому.
Наразі триває розробка методики лікування аденоми простати за допомогою біполярної абляції


Коли варто обрати фокальну терапію - при активному спостереженні
Підсумуємо: не всі пухлини передміхурової залози потребують агресивного лікування. Гіперлікування раку простати може бути невиправданим при неагресивних пухлинах.
Фокальна терапія — сучасний підхід для неагресивних форм раку.
Фокальна терапія може застосовуватися в межах стратегії активного спостереження у пацієнтів із локалізованим раком простати низького ризику, - наголошує лікар-онкоуролог д.мед.н. Вітрук Юрій Васильович.
У таких випадках метод дозволяє цілеспрямовано впливати на клінічно значуще пухлинне вогнище, зберігаючи при цьому більшу частину здорової тканини передміхурової залози.
Це дає змогу відтермінувати або уникнути радикального лікування, зменшити ризик побічних ефектів та зберегти якість життя пацієнта за умови регулярного динамічного контролю (ПСА, мпМРТ, контрольні біопсії).


Консультація лікаря-уролога, онколога, онкохірурга в Києві
Приходьте на консультацію одного з провідних онкоурологів України в Києві, вул. Васильківська 45, Голосіївський район (між метро "Васильківська" та "Виставковий центр").
Попередній запис на прийом та всі питання щодо вартості послуг Ви можете задати за телефонами:
+38 (099) 412 55 95
+38 (073) 465 55 95
+38 (096) 643 55 95
СТАХОВСЬКИЙ
Едуард Олександрович
доктор медичних наук, професор, член-кореспондент НАМН України, лікар-уролог вищої категорії, онколог, дитячий уролог
ВОЙЛЕНКО
Олег Анатолійович
доктор медичних наук, професор, лікар-уролог вищої категорії, онколог, лікар УЗД, лікар-ендоскопіст, дитячий уролог
СТАХОВСЬКИЙ
Олександр Едуардович
доктор медичних наук,
лікар-уролог вищої категорії, онкохірург
ВІТРУК
Юрій Васильович
доктор медичних наук, лікар-уролог вищої категорії, онколог, лікар УЗД, дитячий уролог
Спеціалісти з раку простати в Києві - урологи, онкологи
Записуйтесь на консультацію до провідних лікарів-урологів, онкологів країни - досвідчених фахівців з лікування урологічних та онкоурологічних захворювань, зокрема аденоми та раку простати, доброякісних і злоякісних новоутворень нирки, сечоводів та сечового міхура, та інших захворювань сечовидільної системи.


Чи знаєте Ви, що рак передміхурової залози – це найпоширеніше чоловіче онкозахворювання у світі?
Далі ми розкажемо Вам про основні моменти, які важливо знати про це захворювання:
які причини та симптоми
як правильно діагностувати захворювання
що таке ПСА-тест
з якого віку чоловікам варто здавати аналіз крові на ПСА
яка біопсія краще
які методи лікування є найефективнішими
які нові сучасні патенти українських лікарів є перспективними у лікування раку простати.
Контакти
+38 099 412 55 95
Соціальні медіа
ТОВ "Центр сучасної урології"
Консультації на Васильківській 45, Київ
Медичний центр (стаціонар) Крюківщина, вул. Ярослава Мудрого 51 (3-й поверх)
+38 073 465 55 95
+38 096 643 55 95
E-mail: info@urology.net.ua
Адреси
Ліцензія НАКАЗ МОЗ України №1083 від 07.06.2018
Copyright © 2018-2026 ТОВ "Центр сучасної урології"











